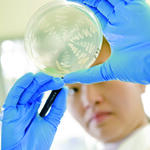
Hefe

Beispielhafte Projekte aus der Fördertätigkeit der DBU
-

Nachhaltige Quartiersentwicklung im Wohnviertel Židlochovice (Tschechische Republik)
Projekt aus der internationalen Förderung
Weiterlesen -

CCHIP-Projekt: Connecting culture, heritage and the IPCC (Intergovernmental Panel on Climate Change)
Projekt aus der internationalen Förderung
Weiterlesen -

Messung der Luftqualität mit Smartphones
Projekt will Schülerinnen und Schülern zur Durchführung von Umweltstudien mit Smartphone und mobiler Messtechnik befähigen und wissenschaftlich begleiten
Weiterlesen -

Phosphor-Rückgewinnung zum Begreifen und Selbermachen
Universität Bremen setzt angewandte Umwelttechnik in Schülerlaboren ein
Weiterlesen -

Effizienter Feinstaubfilter
Entwicklung einer Filterausrüstung zur Senkung des Energieaufwandes beim Betrieb von Feinstaubfiltern durch die Erhöhung der Filtereffizienz und der Standzeit
Weiterlesen -

Biotechnologische Produktion von Cortisol und markierten Referenzsubstanzen
Herstellungsverfahren verzichtet auf Markierung mit radioaktiven Isotopen
Weiterlesen -

Gewinnung pharmarelevanter Zucker für die Herstellung von Impfstoffen und Medikamenten
Eine Vielzahl von (antiviralen) Wirkstoffen, Medikamenten und Impfstoffen sind Abkömmlinge von Kohlenhydraten (Zuckern) oder selbst Kohlenhydrate
Weiterlesen